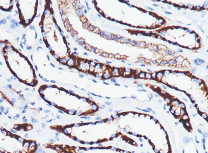

Ksp-Cadherin抗体试剂
Ksp-Cadherin抗体试剂
肾特异性钙黏附蛋白
产品描述
Ksp-Cadherin(肾脏特异性钙黏蛋白)抗体 是一种特异性靶向肾小管上皮细胞和集合管细胞基底侧膜的新型钙黏蛋白家族成员,在肾脏组织中具有高度特异性(不表达于肾小球、间质细胞或血管)。该抗体在肾癌病理诊断中表现重要价值:研究显示其膜性染色模式在嫌色细胞癌(96-100%阳性)与嗜酸细胞瘤(6-95%阳性)中存在显著差异,为这两种形态相似肿瘤的鉴别诊断提供有效依据。值得注意的是,不同研究间阳性率差异提示需结合其他标志物综合判断。该抗体亦可用于探索肾细胞癌中钙黏蛋白(如E-Cadherin、Cadherin-6等)表达缺失与肿瘤分化程度及淋巴结转移的相关性。
参考文献
产品信息
备案名称:
肾特异性钙黏附蛋白(Ksp-Cadherin)抗体试剂
备案证号:
粤深械备 20221668
产品型号:
DMRD0213
适用:
阳性部位:
细胞膜
预 处 理:
产品规格
| 类型 | 即用型 | 浓缩型 | ||||
| 规格 | 1ml | 3ml | 6ml | 10ml | 0.1ml | 0.2ml |


